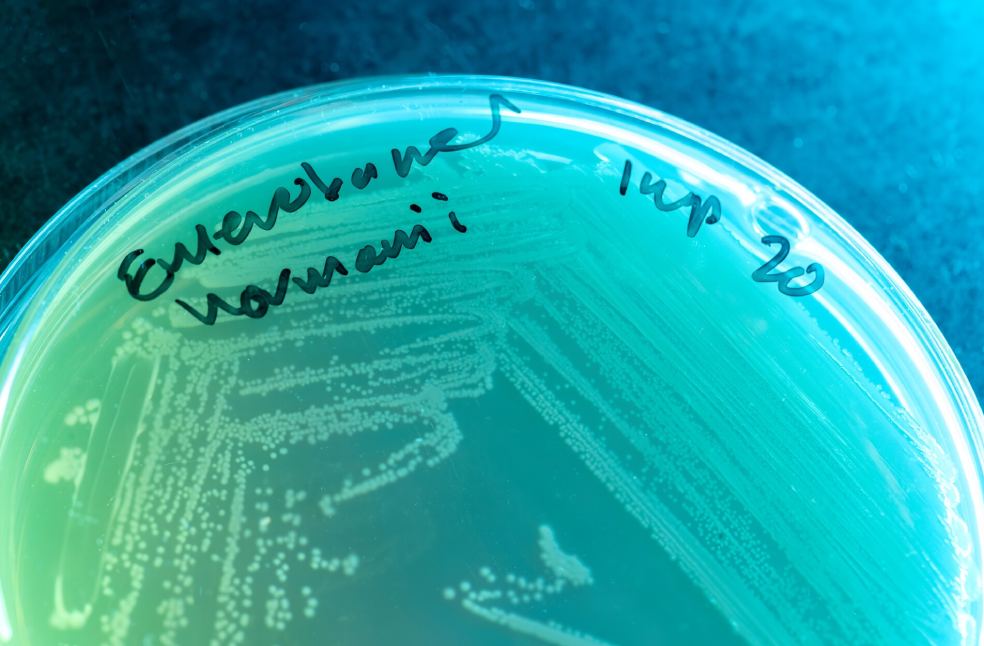
drug-resistant infections

London: The UK has unveiled a major $59.2 million (£45 million) initiative that will use advanced artificial intelligence to accelerate the discovery of new antibiotics and combat the fast-growing threat of drug-resistant infections.
The programme, a collaboration between the Fleming Initiative and pharmaceutical giant GSK, aims to outpace evolving superbugs by combining cutting-edge computing with laboratory research. Scientists say the project represents one of the biggest UK investments ever made in antibiotic innovation.
Drug-resistant infections, often called the silent pandemic are now directly responsible for around one million deaths each year and contribute to millions more. With the overuse of antibiotics helping bacteria evolve rapidly, experts warn that the crisis is already unfolding in hospitals and conflict zones worldwide.
Dr. Andrew Edwards of Imperial College London, one of the lead researchers, will use AI to tackle notoriously tough Gram-negative bacteria such as E. coli and Klebsiella pneumoniae. These pathogens have a unique outer layer that blocks or expels antibiotics, making them extremely difficult to treat.
His team will test molecules with varied chemical structures to see which ones can enter and remain inside these bacteria. Those findings will train AI models capable of predicting and eventually designing antibiotics that can bypass bacterial defences.
Researchers say the consequences of untreatable infections are already visible. Cases emerging from the conflict in Ukraine show wounds that cannot be treated with any existing antibiotic, forcing amputations in patients with no other option.
The Fleming Initiative, named after penicillin discoverer Sir Alexander Fleming will also use AI to forecast how dangerous strains emerge and spread, mirroring weather-prediction models. Another arm of the project will turn AI toward tackling deadly fungal infections, beginning with Aspergillus, a common mould that can become life-threatening for people with weakened immune systems.

Alison Holmes, director of the Fleming Initiative, says society has long taken antibiotics for granted. Alison Holmes noted that, “Whether it’s that time we stepped on a nail, had a C-section, a UTI or an STI, we all depend on them.”
GSK’s chief scientific officer Tony Wood said the partnership aims to open up new approaches, both to discover novel antibiotics and anticipate resistance before it becomes widespread.
The UK currently detects nearly 400 new antibiotic-resistant infections every week. With AI already being deployed in the US and Canada to design or shortlist new antibiotic candidates, researchers hope this new investment will place the UK at the forefront of the global fight against superbugs.

